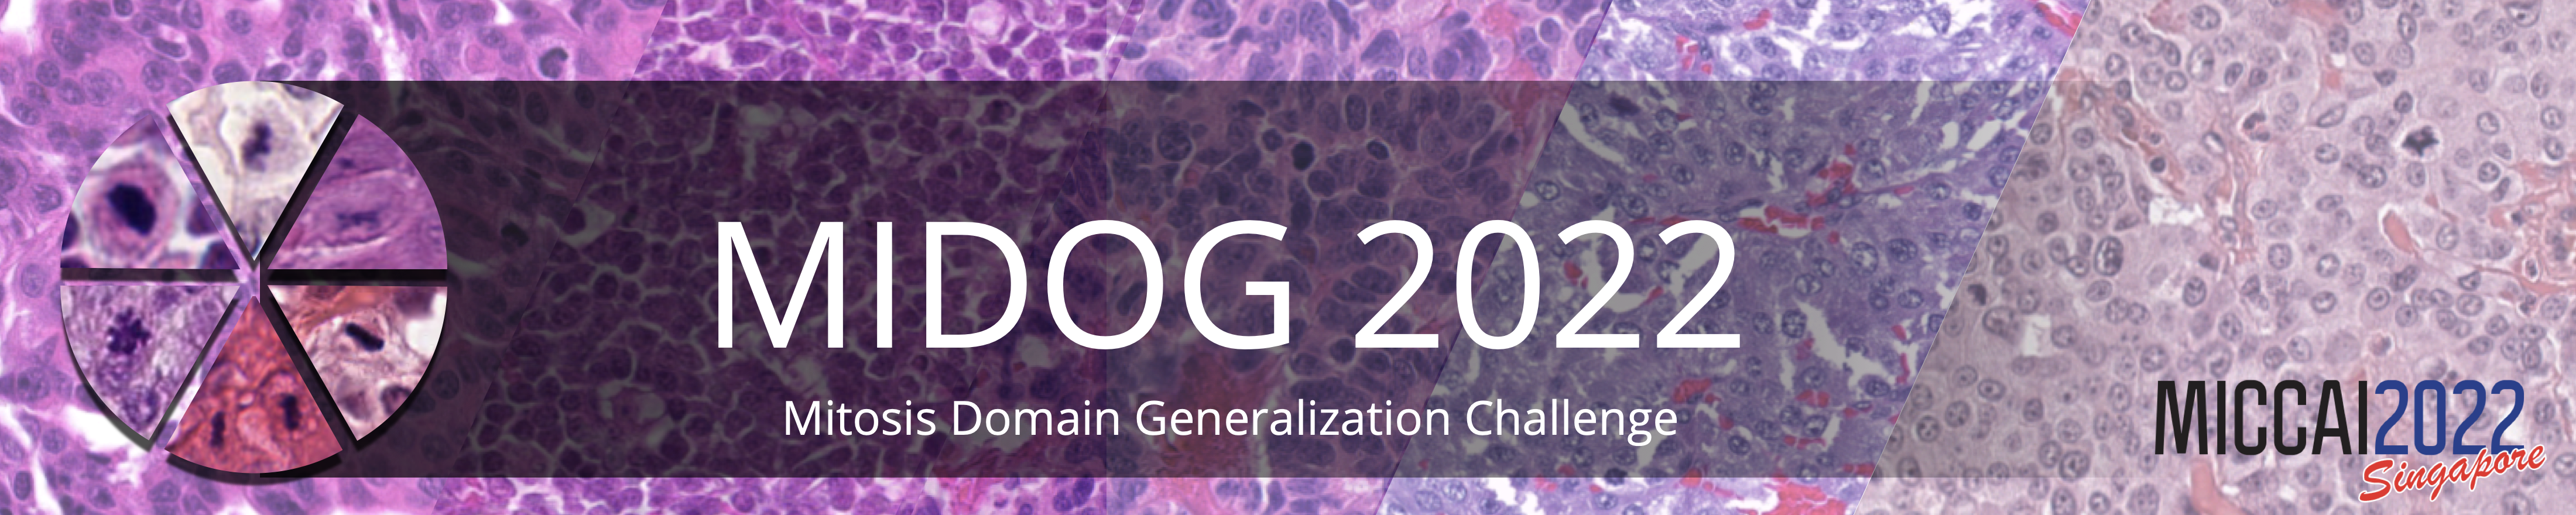
Challenge Banner

MItosis DOmain Generalization Challenge 2022¶
Latest news ^3:
The MIDOG 2022 challenge report was published in Medical Image Analysis (Elsevier). Please find the paper here: link.
Latest news^2:
Unfortunately, we've had an error in the previous calculation of the additional Average Precision (AP) metric. Please find out all details in this blog post.
Latest news:
We are excited to announce that the MIDOG++ dataset, an extension of the MIDOG2022 training data set has just been released. We have published a data descriptor paper for a full description of the data set. To get a glimpse, we recommend reading the blog post about it
This is the MIDOG 2022 microscopy domain generalization challenge!
Website: https://midog.deepmicroscopy.org
Motivation:
- Mitosis detection is a key component of tumor prognostication for various tumors.
- Modern deep learning architectures provide detection accuracies for mitosis that are on the level of human experts.
- Mitosis is known to be relevant for many tumor types, yet, when trained on one tumor / tissue type, the performance will typically drop significantly on another.
Scope:
- Detect mitotic figures (cells undergoing cell division) from histopathology images (object detection).
- You will be provided with images from 6 different tumor types, 5 out of which are labeled. In total the set consists of 405 cases and includes 9501 mitotic figure annotations in the training set.
- Evaluation will be done on ten different tumor types with the F1 score as main metric.
How to participate:
- Register on the challenge website and download the data set.
- Select a track (see below) that you want to participate in.
- Submit docker container(s) with your algorithm(s) (template provided here: https://github.com/DeepPathology/MIDOG_reference_docker).
- Provide a short paper (preprint) about your method. A template can be found under this link.
- Note: Only your own work will qualify as a submission.
Tracks:
- There's different ways to approach this task, thus we split up the challenge into two tracks that participants can participate in (either in one or in both).
- Track 1 prohibits the use of any additional (i.e. not provided by the challenge) data and also any kind of manual or semi-automatic generation of any kind of label information.
- In Task 2, use of any publicly available data sets and additional labels is permitted. If you want to make use of previously private labels, please have a look at the related blog post.
Important Dates:
April 20: Training set releasedAugust 5th: Preliminary test set
available~~August 15th~~ August 23th: Deadline for registration of
participants~~August 17th~~ August 25th: Deadline for trial runs on
preliminary test set (extended)August 29th August 30th: Docker
container submission (with link to published preprint) (extended)Sept
18-22: Announcement of results at MICCAI 2022
Publications and Prizes:All participants of the MIDOG challenge may
submit a short LNCS Springer paper (up to 4 pages) with a deadline of
three weeks after the workshop, which will be subject to peer
review. Top performing teams will be invited to contribute to a
challenge overview paper, which will be submitted to a high impact
journal (MedIA/TMI). We are currently reaching out to sponsors for prize
money.
Organizers:Marc Aubreville, Technische Hochschule Ingolstadt,
GermanyChristof Bertram, Institute of Pathology, University of
Veterinary Medicine, Vienna, AustriaMitko Veta, Medical Image Analysis
Group, TU Eindhoven, The NetherlandsNikolas Stathonikos, Pathology
Department, UMC Utrecht, The NetherlandsSamir Jabari, Institute of
Neuropathology, University Hospital Erlangen, GermanyKatharina
Breininger, Department Artificial Intelligence in Biomedical
Engineering, Friedrich-Alexander- Universität Erlangen-Nürnberg,
Germany